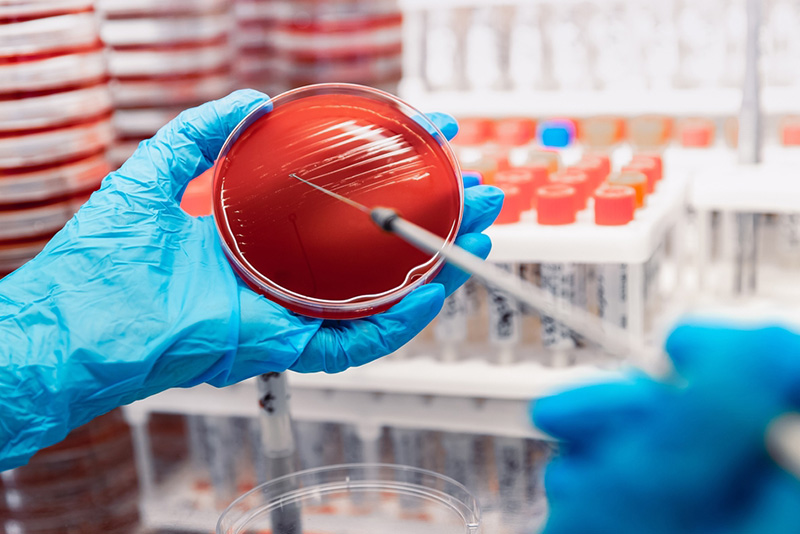
Nuôi Cấy Vi Sinh Vật Là Gì? Ý Nghĩa, Quy Trình, Phân Loại Phương Pháp Nuôi Cấy Vi Sinh Phổ Biến
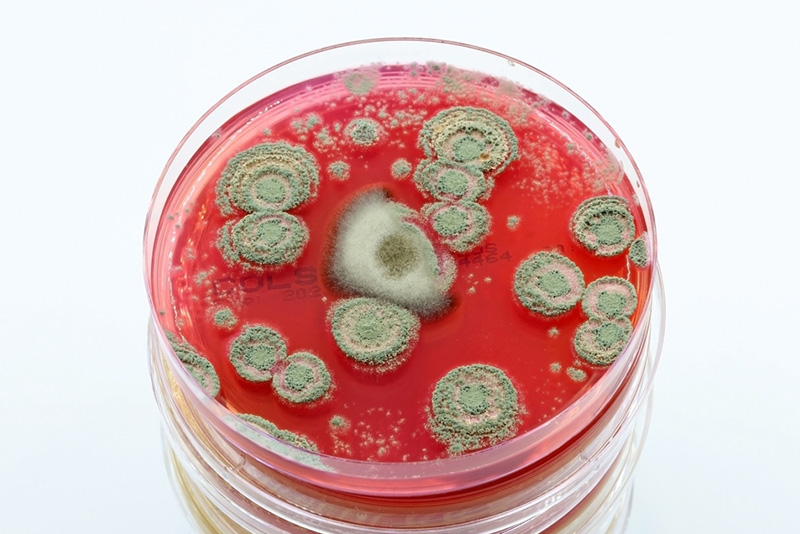
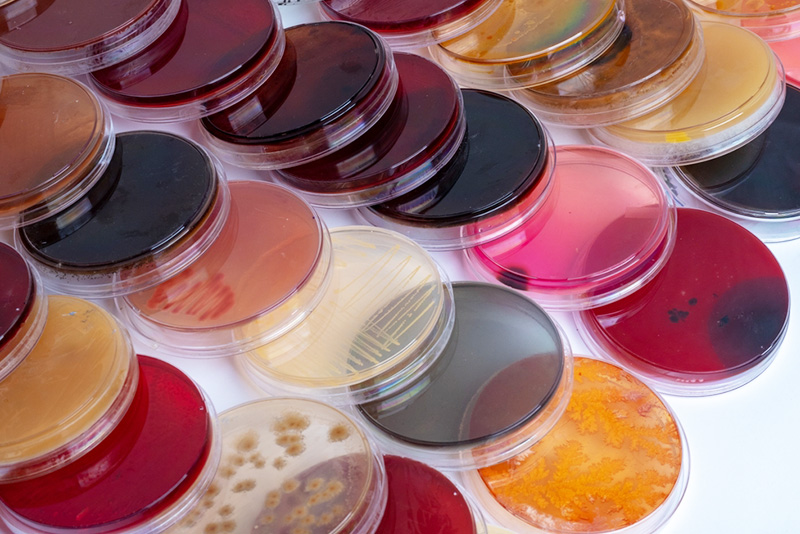
Nuôi Cấy Vi Sinh Vật Là Gì? Ý Nghĩa, Quy Trình, Phân Loại Phương Pháp Nuôi Cấy Vi Sinh Phổ Biến
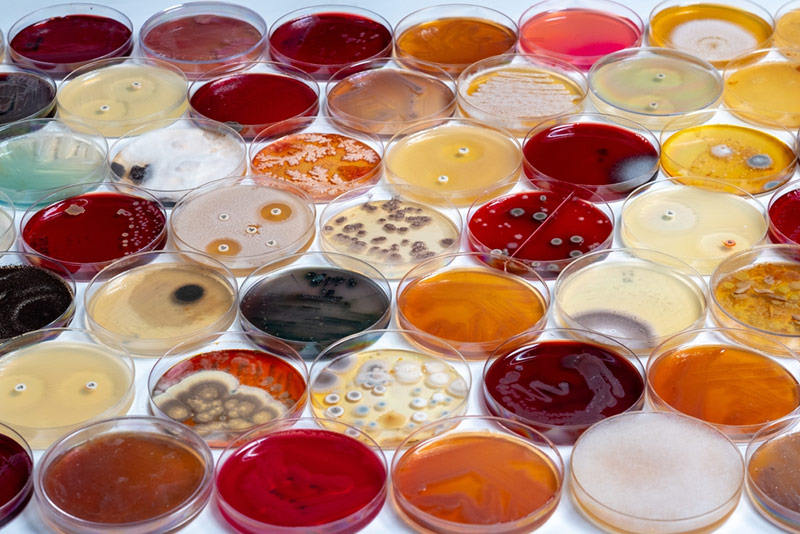

Nuôi Cấy Vi Sinh Vật Là Gì? Ý Nghĩa, Quy Trình, Phân Loại Phương Pháp Nuôi Cấy Vi Sinh Phổ Biến
Vi sinh vật tuy nhỏ bé nhưng đóng vai trò vô cùng quan trọng trong nhiều lĩnh vực từ y học, công nghiệp thực phẩm đến nghiên cứu khoa học và môi trường. Để nghiên cứu, định danh và ứng dụng vi sinh vật, kỹ thuật nuôi cấy là công cụ nền tảng không thể thiếu. Vậy nuôi cấy vi sinh vật là gì? Ý nghĩa, quy trình ra sao, có những phương pháp nuôi cấy vi sinh nào phổ biến hiện nay? Bài viết dưới đây sẽ giúp bạn hiểu rõ hơn về kỹ thuật quan trọng này.
Nuôi cấy vi sinh vật là gì?
Nuôi cấy vi sinh vật là quy trình kỹ thuật tạo ra môi trường thích hợp để nuôi dưỡng, nhân số lượng vi sinh vật, giúp vi sinh vật có thể sinh trưởng và phát triển trong điều kiện được kiểm soát chặt chẽ tại phòng thí nghiệm hoặc quy mô công nghiệp. Đây là kỹ thuật cơ bản và thiết yếu trong vi sinh học, cho phép các nhà khoa học quan sát, nghiên cứu đặc tính cũng như ứng dụng vi sinh vật vào thực tiễn.
Quá trình này đòi hỏi phải cung cấp đầy đủ các yếu tố sinh học cần thiết cho vi sinh vật, bao gồm nguồn dinh dưỡng phù hợp như carbon, nitơ, vitamin và khoáng chất, cùng với các điều kiện môi trường tối ưu về nhiệt độ, độ ẩm, pH và khí quyển.
Môi trường nuôi cấy có thể ở dạng rắn (thạch), bán rắn hoặc lỏng (nước canh), tùy thuộc vào mục đích sử dụng và loại vi sinh vật cần nghiên cứu.
Kỹ thuật nuôi cấy vi sinh không chỉ giúp phát hiện và định danh các vi sinh vật gây bệnh mà còn hỗ trợ sản xuất các sản phẩm sinh học có giá trị như kháng sinh, enzyme, vaccine và nhiều ứng dụng khác trong đời sống.

Vai trò và ý nghĩa của nuôi cấy vi sinh vật là gì?
Trong y học và chẩn đoán bệnh
Nuôi cấy là công cụ chính để phát hiện, phân lập và định danh các vi sinh vật gây bệnh từ mẫu bệnh phẩm như máu, nước tiểu, đờm, mủ. Kết quả nuôi cấy giúp bác sĩ xác định chính xác tác nhân gây bệnh, từ đó chọn lựa phương pháp điều trị và kháng sinh phù hợp, tránh tình trạng kháng thuốc ngày càng gia tăng.
Trong công nghiệp thực phẩm
Vi sinh vật được nuôi cấy để sản xuất các sản phẩm lên men như sữa chua, rượu, bia, nước tương, phô mai. Ngoài ra, chúng còn được ứng dụng để sản xuất enzyme thực phẩm cũng như các chất tạo hương vị tự nhiên.
Kỹ thuật nuôi cấy còn được sử dụng trong các phòng kiểm nghiệm để đánh giá mức độ ô nhiễm vi sinh trong thực phẩm, bao gồm tổng số vi sinh vật hiếu khí, Coliform, E.coli, Salmonella, Listeria và các vi sinh vật gây bệnh khác. Kết quả giúp nâng cao chất lượng và độ an toàn của thực phẩm, đảm bảo thực phẩm đạt tiêu chuẩn an toàn vệ sinh trước khi đưa ra thị trường, bảo vệ sức khỏe người tiêu dùng.

Trong nghiên cứu khoa học
Kỹ thuật nuôi cấy cho phép các nhà khoa học nghiên cứu chu trình sống, cơ chế tăng trưởng, quá trình trao đổi chất và đặc tính di truyền của vi sinh vật. Đây là nền tảng để phát triển các công nghệ sinh học tiên tiến, từ biến đổi gen đến tạo ra các chủng vi sinh vật có ích cho con người.

Trong nông nghiệp và môi trường
Vi sinh vật được nuôi cấy để tạo ra các chế phẩm sinh học hỗ trợ cây trồng như vi khuẩn cố định đạm, phân giải lân, hoặc các chủng vi sinh vật đối kháng với mầm bệnh. Trong xử lý môi trường, vi sinh vật được sử dụng để phân hủy chất thải, làm sạch nước thải và xử lý đất ô nhiễm, góp phần bảo vệ môi trường sống.
Nguyên tắc cơ bản của quy trình nuôi cấy vi sinh
- Vô trùng: Thao tác trong tủ cấy, dùng dụng cụ và môi trường vô trùng để ngăn tạp nhiễm.
- Môi trường: Cung cấp đủ dinh dưỡng (Carbohydrate, Nitơ, Phosphor) và điều kiện vật lý tối ưu (nhiệt độ 25-30°C, pH 6-8, độ ẩm).
- Nhân sinh khối: Làm tăng số lượng vi sinh vật lên nhiều lần để dễ dàng quan sát, phân tích.
Quy trình, phương pháp nuôi cấy vi sinh vật chi tiết

Quy trình nuôi cấy vi sinh vật tiêu chuẩn bao gồm các bước:
- Chuẩn bị môi trường (tiệt trùng)
- Chuẩn bị mẫu (rắn, lỏng, không khí)
- Xử lý mẫu
- Cấy mẫu trên đĩa Petri
- Ủ mẫu với tủ ấm
- Quan sát và đếm khuẩn lạc
- Hủy mẫu sau khi hoàn thành ( tiệt trùng)
Bước 1: Chuẩn bị, lựa chọn môi trường nuôi cấy phù hợp
Trong bước chuẩn bị môi trường, việc lựa chọn môi trường nuôi cấy vi sinh đúng là yếu tố quyết định thành công của quá trình nuôi cấy. Có thể phân loại môi trường nuôi cấy vi sinh theo 3 cách:
Phân loại theo tính nhất quán vật lý
- Môi trường rắn: Hàm lượng thạch cao (1.5-2.0%), tạo bề mặt để phân lập khuẩn lạc (ví dụ: Thạch dinh dưỡng, Thạch máu).
- Môi trường bán rắn: Hàm lượng thạch thấp (<0.5%), tạo độ đặc nhẹ.
- Môi trường lỏng (Canh): Không có chất làm đông, nuôi cấy nhiều vi sinh vật (ví dụ: Luria Broth).
Phân loại theo mục đích sử dụng
- Môi trường cơ bản: Cung cấp dinh dưỡng chung cho nhiều loại vi sinh vật.
- Môi trường tăng sinh: Bổ sung máu, huyết thanh, máu, mô để nuôi cấy nhóm vi sinh vật khó tính.
- Môi trường chọn lọc: Chứa chất ức chế (muối mật, kháng sinh, thuốc nhuộm) để chỉ cho nhóm vi sinh vật mong muốn phát triển (ví dụ: MacConkey, SS).
- Môi trường định danh: Giúp xác định đặc tính sinh hóa (ví dụ: Thạch định danh).
- Môi trường vi sinh chuyển: Bảo quản mẫu trong quá trình vận chuyển, duy trì khả năng sống của vi sinh vật, ngăn ngừa khô, nhiễm khuẩn và tăng sinh quá mức
- Môi trường kỵ khí: Thiết kế cho vi khuẩn kỵ khí bắt buộc, loại bỏ hoặc giảm thiểu oxy hòa tan, bổ sung chất khử (thioglycollate, cysteine), thêm hemin và vitamin K
- Môi trường phân tích: Giúp định lượng vitamin, amino acid, Xét nghiệm hoạt lực kháng sinh, Phân tích hoạt tính enzyme, Nghiên cứu nhu cầu dinh dưỡng
- Môi trường Phân Biệt/Chỉ Thị:Có chất ức chế để chỉ chọn lọc một loại vi sinh vật nhất định phát triển
Phân loại theo thành phần môi trường
- Môi trường không tổng hợp (Tự nhiên): Chứa các thành phần phức tạp, không rõ ràng (ví dụ: Dịch chiết thịt).
- Môi trường tổng hợp (Xác định): Thành phần hóa học tinh khiết, biết rõ từng chất (dùng trong nghiên cứu).
- Môi trường bán tổng hợp: gồm các chất tự nhiên và các chất hóa học đã iết thành phần và số lượng
Bước 2: Chuẩn bị mẫu vi sinh
Giai đoạn thứ hai và cũng quan trọng không kém là chuẩn bị mẫu vi sinh đúng kỹ thuật.
- Đối với mẫu bệnh phẩm: cần được lấy đủ lượng, đại diện cho vị trí tổn thương, và tránh nhiễm vi khuẩn thường trú hoặc từ môi trường xung quanh.
- Đối với mẫu thực phẩm hoặc môi trường: cần pha loãng mẫu máy pha loãng mẫu vi sinh, để đưa nồng độ vi sinh vật về mức phù hợp cho việc đếm và phân tích.
Các dạng mẫu thường gặp trong nuôi cấy vi sinh:
Khi thực hiện nuôi cấy, chúng ta thường bắt gặp 3 dạng mẫu chính:
Mẫu dạng dịch mẫu chỉ định (mẫu lỏng)
Đây là dạng mẫu đã được xác định trước chứa vi sinh vật cụ thể cần phân tích. Dạng mẫu này thường được sử dụng trong các xét nghiệm chẩn đoán hoặc kiểm tra chất lượng sản phẩm, giúp tiết kiệm thời gian và tăng độ chính xác trong quá trình định danh.
Dạng nuôi cấy trên bề mặt môi trường rắn
Vi sinh vật được cấy trên bề mặt lớp thạch mỏng trong đĩa petri hoặc ống nghiệm nghiêng. Phương pháp này tương tự như việc gieo hạt lên đất, cho phép vi sinh vật phát triển thành các khuẩn lạc riêng biệt, dễ dàng quan sát và định danh dựa trên hình thái đặc trưng của từng loài.
Dạng nuôi cấy sâu trong môi trường rắn
Khác với dạng bề mặt, vi sinh vật được đưa vào bên trong lớp thạch mềm trong ống nghiệm. Phương pháp này đặc biệt phù hợp cho việc nuôi cấy vi khuẩn kỵ khí – những vi sinh vật không thể phát triển trong môi trường có oxy, hoặc để nghiên cứu khả năng di động của vi khuẩn.
Các mẫu trên sẽ được trải qua bước xử lý mẫu để chuyển sang bước tiếp theo, chuẩn bị môi trường nuôi cấy vi sinh.
Bước 3: Cấy mẫu trên đĩa petri
Việc cấy mẫu trên đĩa petri thường được phân loại theo theo tác cấy, cụ thể như sau:
- Phương pháp cấy điểm – đổ đĩa (Pour plating): Trộn vi sinh vật vào thạch nóng chảy đã làm nguội xuống 45-50°C, rồi đổ vào đĩa Petri, cả trên bề mặt và bên trong lớp thạch, phù hợp cho việc nuôi cấy và đếm vi sinh vật có mật độ cao.
- Phương pháp cấy ria – trải đĩa (Streak plating): Sử dụng que trải vô trùng hoặc que kính chữ L phết đều mẫu đã pha loãng lên toàn bộ bề mặt môi trường thạch, cho phép vi sinh vật phân bố đồng đều trên bề mặt, thuận lợi cho việc đếm khuẩn lạc chính xác.
- Phương pháp Cấy zích zắc – cấy phân vùng (Zig-zag): Dùng que cấy vòng để cấy theo đường zích zắc trên bề mặt thạch, chia thành 3-4 vùng. Mật độ vi sinh vật giảm dần từ vùng 1 đến vùng cuối, giúp tách riêng các khuẩn lạc để dễ dàng quan sát và lựa chọn khuẩn lạc đơn thuần phục vụ định danh. Thích hợp cho nuôi cấy vi khuẩn, nấm men.
- Cấy truyền/ chuyển cấy (Transport): Chuyển một lượng vi sinh vật từ môi trường này sang môi trường khác bằng que cấy, pipet.
- Phương pháp màng lọc (Membrane Filtration): Dùng bơm chân không để lọc mẫu qua màng lọc cellulose có kích thước lỗ 0,45 micromet, sau đó đặt màng lên bề mặt môi trường nuôi cấy. Phương pháp này đặc biệt hiệu quả với mẫu có mật độ vi sinh vật thấp như nước uống, nước tinh khiết.
Bước 4: Ủ ấm mẫu bằng tủ ấm
Sau khi cấy, các đĩa petri hoặc ống nghiệm được lật ngược (đối với đĩa petri) và đặt vào tủ ấm với điều kiện phù hợp.
Đa số vi khuẩn gây bệnh cần nhiệt độ 35-37°C, trong khi nấm men và nấm mốc phát triển tốt ở 25-30°C. Thời gian ủ thường dao động từ 24-72 giờ, tùy vào loại vi sinh vật.
Một số vi sinh vật đặc biệt như Neisseria gonorrhoeae và Neisseria meningitidis cần môi trường giàu CO2 5% để phát triển.
Bước 5: Quan sát và đếm khuẩn lạc
Sau thời gian ủ ấm, tiến hành quan sát và đếm số lượng khuẩn lạc xuất hiện trên môi trường. Mỗi khuẩn lạc được coi là phát triển từ một tế bào vi sinh vật ban đầu. Kết quả được tính theo công thức:
CFU/ml hoặc CFU/g = Số khuẩn lạc đếm được × Hệ số pha loãng ÷ Thể tích mẫu cấy.
Để đảm bảo độ chính xác, chỉ đếm các đĩa có số khuẩn lạc từ 30-300. Đĩa có quá ít hoặc quá nhiều khuẩn lạc đều ảnh hưởng đến độ tin cậy của kết quả. Ngoài ra, cần chú ý quan sát hình thái khuẩn lạc, màu sắc, kích thước, bề mặt qua kính hiển vi để nhận định sơ bộ về loại vi sinh vật.
Bước 6: Định danh vi sinh vật
Dựa vào đặc điểm hình thái khuẩn lạc, người làm xét nghiệm lựa chọn các khuẩn lạc nghi ngờ để thực hiện các xét nghiệm định danh. Các phương pháp phổ biến bao gồm nhuộm Gram để phân biệt vi khuẩn Gram dương và Gram âm, xét nghiệm sinh hóa để xác định khả năng lên men đường, tạo enzyme, các xét nghiệm miễn dịch, hoặc sử dụng kỹ thuật sinh học phân tử như PCR để định danh chính xác đến loài.
Bước 7: Tiệt trùng mẫu, xử lý mẫu thải sau nuôi cấy
Xử lý các mẫu thải, tiệt trùng các đĩa petri chứa thạch agar nuôi cấy vi sinh bằng nồi hấp tiệt trùng ở nhiệt độ hấp tiệt trùng tiêu chuẩn ở 121 độ C, trong khoảng thời gian tối thiểu 20 phút để tái sử dụng đĩa petri, cũng như đảm bảo an toàn trong phòng thí nghiệm vi sinh.

Các thiết bị cần thiết trong phòng nuôi cấy vi sinh
Để quá trình nuôi cấy được thực hiện tối ưu, cần được thực hiện trong phòng nuôi cấy chuyên dụng. Dưới đây là một số thiết bị cần có trong phòng thiết bị nuôi cấy vi sinh:
Thiết bị chuyên dụng:
Tủ an toàn sinh học (Biosafety Cabinet)
- Chức năng: Bảo vệ mẫu, người thao tác và môi trường
- Phân loại: Class I, II, III tùy mức độ nguy hiểm
- Ứng dụng: Thao tác vô trùng, cấy chuyền vi sinh vật

Nồi hấp tiệt trùng (Autoclave)
- Nguyên lý: Khử trùng bằng hơi nước áp lực cao (121°C, 15 psi)
- Dung tích: 20-200 lít
- Thời gian: 15-30 phút/mẻ
- Ứng dụng: Khử trùng môi trường, dụng cụ, chất thải

Tủ ấm (Incubator)
- Phân loại:
- Tủ ấm thường (nhiệt độ)
- Tủ ấm CO2 (nhiệt độ + khí quyển)
- Tủ ấm lắc (nhiệt độ + khuấy trộn)
- Dải nhiệt độ: 5-80°C
- Độ chính xác: ±0.1-0.5°C

Kính hiển vi
- Loại: Quang học, huỳnh quang, điện tử
- Độ phóng đại: 40x-1000x (quang học)
- Ứng dụng: Quan sát hình thái vi sinh vật, nhuộm Gram

Máy đếm khuẩn lạc tự động
- Công nghệ: Phân tích hình ảnh AI
- Tốc độ: 100-300 đĩa/giờ
- Độ chính xác: >95%
- Lợi ích: Tiết kiệm thời gian, giảm sai số con người

Dụng cụ tiêu hao phòng vi sinh
- Đĩa petri: Nhựa hoặc thủy tinh, đường kính 90-150mm
- Ống nghiệm: Thủy tinh chịu nhiệt, nhiều kích cỡ
- Que cấy: Kim loại hoặc nhựa dùng một lần
- Pipet: Tự động hoặc thủ công, nhiều thể tích
- Màng lọc: Cellulose hoặc PVDF, 0.22-0.45 μm
Các yếu tố ảnh hưởng đến quá trình nuôi cấy
Thành phần môi trường dinh dưỡng
Mỗi loại vi sinh vật có nhu cầu dinh dưỡng riêng biệt. Môi trường cần cung cấp đủ nguồn carbon, nitơ, phospho, lưu huỳnh, các ion kim loại và vitamin cần thiết. Một số vi sinh vật có khả năng tự tổng hợp hầu hết các chất cần thiết, trong khi một số khác lại đòi hỏi môi trường phong phú với nhiều yếu tố tăng trưởng đặc biệt.
Độ pH môi trường
Độ pH là yếu tố quan trọng ảnh hưởng đến hoạt động enzyme và quá trình trao đổi chất của vi sinh vật. Hầu hết vi khuẩn phát triển tốt ở pH trung tính từ 6,5-7,5, trong khi nấm men và nấm mốc thích nghi với môi trường acid nhẹ từ pH 4-6. Một số loài đặc biệt có thể sinh trưởng ở pH cực acid hoặc cực kiềm.
Nhiệt độ nuôi cấy
Nhiệt độ ảnh hưởng trực tiếp đến tốc độ phản ứng sinh hóa và tăng trưởng của vi sinh vật. Vi khuẩn ưa lạnh phát triển tốt dưới 20°C, vi khuẩn ưa ấm từ 20-40°C, và vi khuẩn ưa nhiệt có thể sinh trưởng ở 50-60°C hoặc cao hơn. Việc duy trì và kiểm soát nhiệt độ ổn định trong suốt quá trình nuôi cấy là điều kiện tiên quyết để đảm bảo kết quả chính xác.
Nhu cầu oxy và khí quyển
Dựa vào nhu cầu oxy, vi sinh vật được chia thành nhóm hiếu khí cần oxy để sinh trưởng, nhóm kỵ khí bị ức chế hoặc chết trong môi trường có oxy, nhóm kỵ khí tùy nghi có thể sống cả trong môi trường có và không có oxy, và nhóm vi hiếu khí cần oxy nhưng ở nồng độ thấp hơn khí quyển. Việc cung cấp điều kiện khí quyển phù hợp là yếu tố then chốt quyết định sự thành công của quá trình nuôi cấy.
Thời gian nuôi cấy
Thời gian nuôi cấy phụ thuộc vào tốc độ sinh trưởng của vi sinh vật và mục đích sử dụng. Đa số vi khuẩn gây bệnh cho kết quả sau 18-24 giờ, nhưng một số loài sinh trưởng chậm như vi khuẩn lao có thể cần từ 2-8 tuần. Việc xác định đúng thời gian ủ ấm giúp tối ưu hóa kết quả và tiết kiệm chi phí.
Những lưu ý quan trọng khi nuôi cấy vi sinh vật
Đảm bảo vô trùng tuyệt đối
Đây là nguyên tắc quan trọng nhất trong nuôi cấy vi sinh vật. Mọi thao tác phải được thực hiện trong điều kiện vô trùng, từ khử trùng môi trường bằng hấp áp lực 121°C trong 15-20 phút, khử trùng dụng cụ bằng khô nhiệt hoặc hơi nước áp lực, đến làm việc trong tủ an toàn sinh học và sử dụng kỹ thuật thao tác vô trùng. Bất kỳ sự nhiễm chéo nào cũng có thể làm sai lệch hoàn toàn kết quả.
Lựa chọn môi trường nuôi cấy và điều kiện phù hợp
Việc hiểu rõ đặc tính của vi sinh vật cần nuôi cấy là điều kiện tiên quyết để chọn môi trường, nhiệt độ, pH và điều kiện khí quyển phù hợp. Sử dụng sai môi trường hoặc điều kiện không tối ưu có thể khiến vi sinh vật không phát triển hoặc phát triển kém, dẫn đến kết quả âm tính giả.
Kiểm soát chất lượng
Thực hiện kiểm tra chất lượng môi trường, dụng cụ và quy trình thường xuyên. Sử dụng các chủng chuẩn để kiểm tra tính năng của môi trường, tủ ấm và các thiết bị khác. Ghi chép đầy đủ các thông số và kết quả để có thể truy xuất nguồn gốc khi cần thiết.
Kỹ thuật và kinh nghiệm nuôi cấy vi sinh
Người thực hiện nuôi cấy cần được đào tạo bài bản về kỹ thuật vi sinh, có khả năng nhận biết hình thái khuẩn lạc, và có kinh nghiệm trong việc xử lý các tình huống phát sinh. Kỹ năng quan sát, phân tích và ra quyết định đóng vai trò quan trọng trong việc đảm bảo kết quả chính xác.
Đảm bảo nguyên tắc an toàn phòng thí nghiệm
Luôn coi các mẫu bệnh phẩm và vi sinh vật nuôi cấy là có khả năng gây bệnh. Tuân thủ nghiêm ngặt các quy định về an toàn sinh học, sử dụng đồ bảo hộ cá nhân, xử lý chất thải đúng quy định và khử trùng toàn bộ dụng cụ sau khi sử dụng.
Sai lầm thường gặp và cách khắc phục

Dưới đây là một số sai lầm có thể gặp phải trong quay trình nuôi cấy vi sinh trong phòng thí nghiệm:
Lấy mẫu không đúng thời điểm hoặc vị trí
- Hậu quả: Kết quả âm tính giả hoặc dương tính giả
- Khắc phục:
- Lấy mẫu trước khi dùng kháng sinh (với mẫu lâm sàng)
- Lấy từ vị trí có tổn thương rõ ràng
- Tránh lấy vào vi khuẩn thường trú
Bảo quản mẫu không đúng cách
- Hậu quả: Vi sinh vật chết hoặc tăng trưởng không kiểm soát
- Khắc phục:
- Mẫu máu: Nuôi cấy ngay hoặc giữ ở nhiệt độ phòng
- Mẫu nước tiểu: Nuôi cấy trong 2 giờ hoặc bảo quản 4°C
- Mẫu phân: Sử dụng môi trường vận chuyển
Vi phạm quy tắc vô trùng
- Hậu quả: Nhiễm tạp, kết quả sai lệch
- Khắc phục:
- Làm việc trong tủ an toàn sinh học
- Khử trùng bề mặt làm việc bằng cồn 70%
- Đốt que cấy đến đỏ trước khi sử dụng
- Không nói chuyện khi thao tác
Ủ ấm sai nhiệt độ hoặc thời gian
- Hậu quả: Vi sinh vật không phát triển hoặc phát triển quá mức
- Khắc phục:
- Kiểm tra nhiệt độ tủ ấm hàng ngày
- Sử dụng nhiệt kế chuẩn
- Đọc kết quả đúng thời điểm theo quy trình
Sử dụng sai môi trường nuôi cấy
- Hậu quả: Vi sinh vật mục tiêu không phát triển
- Khắc phục:
- Tham khảo bảng chọn môi trường theo loại bệnh phẩm
- Sử dụng nhiều loại môi trường song song
- Kiểm tra chất lượng môi trường trước sử dụng
Nhầm lẫn khuẩn lạc vi sinh vật với tạp nhiễm
- Hậu quả: Bỏ sót tác nhân gây bệnh hoặc báo cáo sai
- Khắc phục:
- Đào tạo kỹ năng nhận diện hình thái khuẩn lạc
- Sử dụng đối chứng âm và dương
- Tham vấn chuyên gia khi nghi ngờ
Tính toán sai số lượng khuẩn lạc
- Hậu quả: Đánh giá sai mức độ nhiễm khuẩn
- Khắc phục:
- Kiểm tra lại công thức tính toán
- Đếm đĩa có 30-300 khuẩn lạc
- Lặp lại thí nghiệm khi kết quả bất thường
Câu hỏi thường gặp về nuôi cấy vi sinh
Câu hỏi 1: Tại sao phải lật ngược đĩa petri khi ủ ấm?
Trả lời: Lật ngược đĩa petri giúp ngăn hơi nước ngưng tụ rơi xuống bề mặt thạch, tránh làm nhòe khuẩn lạc và gây nhiễm chéo giữa các khuẩn lạc. Điều này đặc biệt quan trọng khi ủ ở nhiệt độ 35-37°C, nơi độ chênh lệch nhiệt độ tạo ra hiện tượng ngưng tụ.
Câu hỏi 2: Khi nào cần sử dụng tủ ấm CO2?
Trả lời: Tủ ấm CO2 (5-10% CO2) cần thiết cho:
- Vi khuẩn đòi hỏi cao về dinh dưỡng như Neisseria spp.
- Nuôi cấy tế bào động vật
- Một số vi khuẩn kị khí tùy nghi
- Môi trường cần duy trì pH ổn định qua hệ đệm carbonate
Câu hỏi 3: Có thể nuôi cấy tất cả vi sinh vật trong phòng thí nghiệm không?
Trả lời: Không. Ước tính chỉ 1-10% vi sinh vật trong tự nhiên có thể nuôi cấy được trong phòng thí nghiệm. Nhiều vi sinh vật cần điều kiện đặc biệt phức tạp hoặc phụ thuộc vào sự cộng sinh với các sinh vật khác. Đây là lý do các phương pháp phân tử (PCR, giải trình tự) ngày càng quan trọng.
Câu hỏi 4: Nuôi cấy vi sinh có vai trò gì trong kháng kháng sinh?
Trả lời: Nuôi cấy giúp:
- Xác định vi khuẩn gây bệnh cụ thể
- Thử nghiệm kháng sinh đồ (antibiogram)
- Phát hiện vi khuẩn đa kháng thuốc
- Hướng dẫn bác sĩ lựa chọn kháng sinh phù hợp
- Giám sát xu hướng kháng thuốc trong cộng đồng
Câu hỏi 5: Nuôi cấy vi sinh khác gì với xét nghiệm PCR?
Trả lời:
| Đặc điểm | Nuôi cấy | PCR |
| Thời gian | 24-72 giờ | 2-4 giờ |
| Phát hiện | Vi sinh vật sống | DNA (cả sống và chết) |
| Kháng sinh đồ | Có | Không |
| Độ nhạy | Trung bình | Rất cao |
| Chi phí | Thấp-trung bình | Trung bình-cao |
| Vi sinh vật khó nuôi | Không phát hiện | Phát hiện được |
Kết luận: Hai phương pháp bổ trợ cho nhau, không thay thế hoàn toàn.
Câu hỏi 6: Làm thế nào xử lý khi bị đổ vỡ mẫu bệnh phẩm?
Trả lời: Quy trình xử lý khẩn cấp:
- Không hoảng sợ, không chạm trực tiếp
- Che phủ vùng đổ bằng khăn giấy có tẩm chất khử trùng
- Để yên 15-30 phút để khử trùng
- Dọn dẹp từ ngoài vào trong bằng dụng cụ
- Khử trùng bề mặt bằng cồn 70% hoặc Javel
- Báo cáo cho người phụ trách phòng thí nghiệm
- Rửa tay kỹ bằng xà phòng
Câu hỏi 7: Phải làm gì khi nghi ngờ nhiễm trùng từ phòng thí nghiệm?
Trả lời:
- Ngay lập tức: Rời khỏi khu vực, báo cáo cho supervisor
- Rửa vùng tiếp xúc: Nước xà phòng trong 15 phút
- Đánh giá rủi ro: Xác định loại vi sinh vật và mức độ nguy hiểm
- Theo dõi y tế: Khám sức khỏe, có thể dự phòng kháng sinh
- Ghi chép đầy đủ: Tình huống, thời gian, hành động đã thực hiện
Kết luận
Hy vọng bài viết đã cung cấp cho bạn góc nhìn toàn diện về nuôi cấy vi sinh vật là gì, cũng như quy trình, vai trò, phân loại, cũng như quy trinh nuôi cấy vi sinh phổ biến hiện nay. Bên cạnh đó, Công ty TNHH Thiết bị Hiệp Phát hiện cũng là đơn vị phân phối các dòng thiết bị phòng thí nghiệm vi sinh, từ các thiết bị cơ bản: tủ an toàn sinh học, nồi hấp tiệt trùng, tủ ấm, kính hiển vi, đến thiết bị chuyên sâu hơn như máy đếm khuẩn lạc, đến từ các hãng sản xuất hàng đầu. Nếu quý khách hàng cần tìm hiểu rõ hơn về kỹ thuật nuôi cấy vi sinh, hoặc có nhu cầu xây dựng phòng thí nghiệm vi sinh, đừng ngần ngại liên hệ với Hiệp Phát qua Sđt: 0919.537.653 – Mr. Tú hoặc Email: sales5@thietbihiepphat.com để được hỗ trợ kịp thời.

Để lại thắc mắc, chúng tôi sẽ giải đáp ngay cho bạn



 VN
VN














